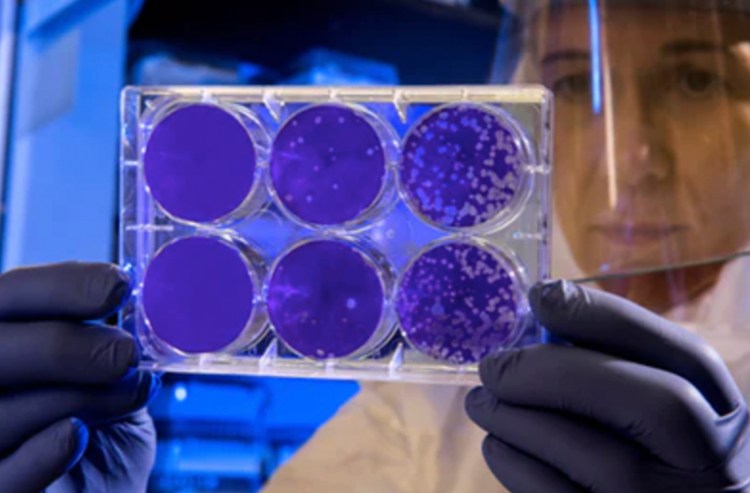

Find the most surprising studies about Humic and Fulvic acids
- Humic Acid, BROAD – SPECTRUM EFFICACY, National Institutes of Health
Natural organic matter is a component of the terrestrial carbon cycle, representing both an important environmental substance and a vital component of the biological energy cycle. The reduced carbon in bioorganic compounds is kinetically stable in the presence of O2 and, as consequence, the release of the chemical energy stored in natural organic matter requires enzymatic catalysis by a complex microbial community. If you wish to read the full study click here.
- Extract on Humic and Fulvic Acid Study
This is a complete resume of Humic and Fulvic Acid, how it can help you, and the benefits for your body. Read the INFO in here.
- Summary
Summary of final report on study about the effects of Humic and Fulvic Acid on Symptoms of Influenza. Read the INFO in here.
- Abouth Humic and Fulvic Acid
All about Humic and Fulvic Acid, learn the basics about the product. This are some questions we have received from our users and their answers given by professionals. Read the INFO in here.

